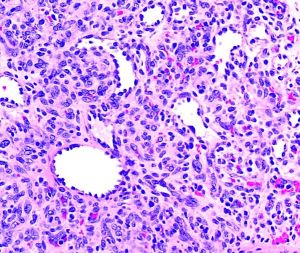

Pyogenic Granuloma
All content on Eyewiki is protected by copyright law and the Terms of Service. This content may not be reproduced, copied, or put into any artificial intelligence program, including large language and generative AI models, without permission from the Academy.
Introduction
Pyogenic granuloma (PG) is a common, non-cancerous growth of blood vessels, first identified by Poncet and Dor in 1897 as "botryomycosis hominis."It is also known as lobular capillary hemangioma, granuloma pyogenicum, and granuloma telangiectaticum.[1] [2][3] The term "lobular capillary hemangioma" is more accurate, as these growths do not produce pus or involve the chronic inflammation typical of granulomas. PG can appear anywhere on the body, most frequently on the skin, affecting men and women equally. However, they are twice as common in the mucous membranes of women, such as the conjunctiva and gingiva, and are often associated with pregnancy.[4] These growths appear as smooth, red-purple bumps, either flat or on a stalk, and can recur after removal. They are also linked to inflammation following strabismus surgery[5] or other eye conditions like styes and chalazia.
Etiology
Pyogenic granulomas are typically seen in the classic polypoid form, but can be divided into other subtypes including dermal, subcutaneous, intravenous, eruptive, and associated with satellites, though these are histologically similar. Risk factors include trauma, pregnancy, medications, and can be found in association with Sturge-Weber syndrome. Causative medications include retinoids, antiretrovirals, and anti-neoplastics.[6][7] Pyogenic granulomas are more common in younger patients.[8]
Although the cause of pyogenic granulomas is unknown, it is postulated that angiogenic dysregulation plays a crucial role in its development. With tissue injury, there may be activation of a neovascular pathway involving FLT4 and the nitric oxide pathway[9] which is evident by increased endothelial nitric oxide synthases.[10] There often is overexpression of VEGF, mutations in BRAF and RAS, as well as development of tumorigenic transcription factors including P-ATF2 and STAT3.[11] With mutations in RAS, it has been suggested that the MAPK/ERK pathway is further affected, thus promoting cell proliferation.[12]
Common risk factors include trauma, pregnancy, and viral infection.[13][14]
Pathology
On gross examination the specimen appears as a fleshy, red hemorrhagic, polypoid or pedunculated nodule. Histologically, pyogenic granulomas appear with lobular vascular proliferations and branching endothelium-lined vessels with inflammation and edema resembling granulation tissue. The overlying epidermis may show ulceration if the lesion has bled and has acanthosis, hyperkeratosis, and hypergranulosis. In mature lesions, a fibromyxoid stroma divides the pyogenic granuloma into lobules.[15] In a regressing pyogenic granuloma, extensive fibrosis can be observed.[15]
Relevant immunohistochemical stains are directly related to its vascular origin, thus PG would be positive for CD34, CD31, Factor VIII, SMA, while negative for HMB-45, which would differentiate the lesion from melanoma.[16]
Diagnosis
Symptoms
Some discomfort or irritation may be felt depending on location of the PG. The lesion will bleed with very little trauma.
Physical Examination
Preliminary diagnosis may be made based on history and clinical appearance. Definitive diagnosis depends on histopathologic exam of a lesion after biopsy.
- Patients will present with a rapidly growing, painless, red polypoid papule or nodule with an average size of 6.5mm,[17] reaching its maximum in a few weeks
- Pyogenic granulomas tend to bleed spontaneously and may resolve with purulence and crusting
- Common sites include the head and neck as well as oral mucous lesions
- In the ocular region, they may arise on the lids, conjunctiva, and rarely the cornea along wound sites either after trauma or post-operatively
Differential Diagnosis
- Angioendothelioma
- Angiosarcoma
- Hemangioendothelioma
- Capillary hemangioma
- Kaposi sarcoma
- Melanoma
- Intravascular papillary endothelial hyperplasia
- Spitz nevus
- Tufted hemangioma
- Neurofibroma
- Cutaneous endometriosis
- Eccrine poroma
Management
In cases where the conjunctiva is affected, topical steroids or beta-blockers may be used first line.[18] Other non-surgical management includes cryotherapy, steroid or bleomycin injection.[19]
Various management techniques have been proposed for pyogenic granuloma. Surgical approaches can include excision, curettage and cauterization, shave excision with laser, and blunt removal with chemical cauterization. Given the possibility of malignancy, surgical excision is preferred as it allows an optimal cosmetic outcome and yields a specimen for pathologic examination.[19]
In lesions that occur during pregnancy, it is recommended to wait until the postpartum period due to high rates of resolution as well as recurrence given intervention.[20]
Prognosis
If untreated, pyogenic granulomas may eventually spontaneously regress and atrophy. Among the various management techniques, surgical excision and cryotherapy have the lowest rates of recurrence at 2.94% and 1.62% respectively. However, given the extension of vasculature within the dermis, recurrence is common.[19] It can rarely recur with surrounding satellite lesions, termed Warner and Wilson-Jones syndrome.[21]
References
- ↑ Ferry AP. Pyogenic granulomas of the eye and ocular adnexa: a study of 100 cases. Transactions of the American Ophthalmological Society. 1989;87:327.
- ↑ Lee J, Sinno H, Tahiri Y, Gilardino MS. Treatment options for cutaneous pyogenic granulomas: a review. Journal of plastic, reconstructive & aesthetic surgery. 2011 Sep 1;64(9):1216-20.
- ↑ Horton JC, Mathers WD, Zimmerman LE. Pyogenic granuloma of the palpebral conjunctiva associated with contact lens wear. Cornea. 1990 Oct 1;9(4):359-61.
- ↑ Harris, M. N., et al. "Lobular capillary hemangiomas: An epidemiologic report, with emphasis on cutaneous lesions." Journal of the American Academy of Dermatology 42.6 (2000): 1012-1016.
- ↑ Espinoza, Gabriela M., and Gregg T. Lueder. "Conjunctival pyogenic granulomas after strabismus surgery." Ophthalmology 112.7 (2005): 1283-1286.
- ↑ Campbell JP, Grekin RC, Ellis CN, Matsuda-John SS, Swanson NA, Voorhees JJ. Retinoid therapy is associated with excess granulation tissue responses. Journal of the American Academy of Dermatology. 1983 Nov 1;9(5):708-13.
- ↑ Bouscarat F, Bouchard C, Bouhour D. Paronychia and pyogenic granuloma of the great toes in patients treated with indinavir. New England Journal of Medicine. 1998 Jun 11;338(24):1776-7.
- ↑ Harris MN, Desai R, Chuang TY, Hood AF, Mirowski GW. Lobular capillary hemangiomas: an epidemiologic report, with emphasis on cutaneous lesions. Journal of the American Academy of Dermatology. 2000 Jun 1;42(6):1012-6.
- ↑ Godfraind C, Calicchio ML, Kozakewich H. Pyogenic granuloma, an impaired wound healing process, linked to vascular growth driven by FLT4 and the nitric oxide pathway. Modern Pathology. 2013 Feb;26(2):247-55.
- ↑ Vassilopoulos SI, Tosios KI, Panis VG, Vrotsos JA. Endothelial cells of oral pyogenic granulomas express eNOS and CD105/endoglin: an immunohistochemical study. Journal of oral pathology & medicine. 2011 Apr;40(4):345-51.
- ↑ Chen SY, Takeuchi S, Urabe K, Hayashida S, Kido M, Tomoeda H, Uchi H, Dainichi T, Takahara M, Shibata S, Tu YT. Overexpression of phosphorylated‐ATF2 and STAT3 in cutaneous angiosarcoma and pyogenic granuloma. Journal of cutaneous pathology. 2008 Aug;35(8):722-30.
- ↑ Lim YH, Douglas SR, Ko CJ, Antaya RJ, McNiff JM, Zhou J. Somatic activating RAS mutations cause vascular tumors including pyogenic granuloma. The Journal of investigative dermatology. 2015 Jun;135(6):1698.
- ↑ El Hayderi L, Paurobally D, Fassotte MF, André J, Arrese JE, Sadzot-Delvaux C, Ruebben A, Nikkels AF. Herpes simplex virus type-I and pyogenic granuloma: a vascular endothelial growth factor-mediated association. Case reports in dermatology. 2013;5(2):236-43.
- ↑ Vázquez‐Martínez OT, González‐Betancourt A, Barboza‐Cerda MC, González‐González SE, Lugo‐Trampe Á, Welsh O, Rojas‐Martínez A, Martínez‐Rodríguez HG, Ocampo‐Candiani J, Ortiz‐López R. Human papillomavirus type 2 associated with pyogenic granuloma in patients without clinical evidence of warts. International journal of dermatology. 2016 Jul;55(7):745-50.
- ↑ 15.0 15.1 Marla V, Shrestha A, Goel K, Shrestha S. The histopathological spectrum of pyogenic granuloma: a case series. Case reports in dentistry. 2016 Jun 12;2016.
- ↑ Humphrey PA, Dehner LP, Pfeifer JD, editors. The Washington manual of surgical pathology. Lippincott Williams & Wilkins; 2008.
- ↑ Patrice SJ, Wiss K, Mulliken JB. Pyogenic granuloma (lobular capillary hemangioma): a clinicopathologic study of 178 cases. Pediatric dermatology. 1991 Dec;8(4):267-76.
- ↑ DeMaria, Lauren N., Nora K. Silverman, and Roman Shinder. "Ophthalmic pyogenic granulomas treated with topical timolol—clinical features of 17 cases." Ophthalmic Plastic & Reconstructive Surgery 34.6 (2018): 579-582.
- ↑ 19.0 19.1 19.2 Lee J, Sinno H, Tahiri Y, Gilardino MS. Treatment options for cutaneous pyogenic granulomas: a review. Journal of plastic, reconstructive & aesthetic surgery. 2011 Sep 1;64(9):1216-20.
- ↑ Manus DA, Sherbert D, Jackson IT. Management considerations for the granuloma of pregnancy. Plastic and reconstructive surgery. 1995 May 1;95(6):1045-50.
- ↑ Senser M, Derancourt C, Blanc D, Van Landuyt H, Laurent R. Granulome pyogénique récurrent ou syndrome de Warner et Wilson-Jones. Archives de pédiatrie. 1997 Jul 1;4(7):653-5.